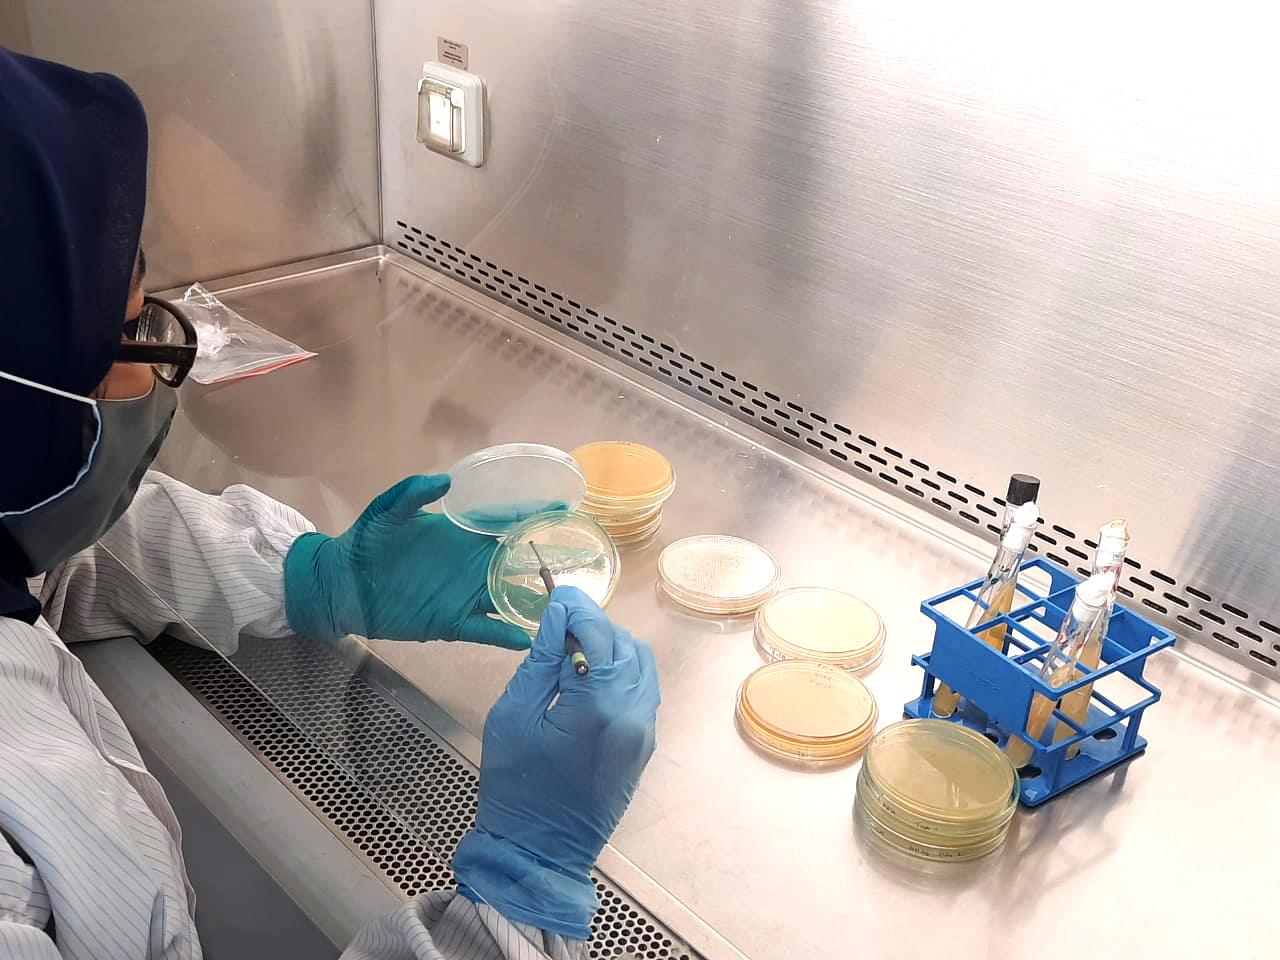

Sudah cukup lama ikan nila di kalangan pembudidaya nasional diserang oleh penyakit mematikan bernama Motile Aeromonas Septicemia (MAS) dan Streptococcosis. Padahal, ikan nila masuk dalam salah satu ikan air tawar konsumsi primadona di masyarakat Indonesia. Ikan yang berasal dari Sungai Nil, Afrika Utara ini telah dijuluki water chicken karena dagingnya banyak diminati sebagai konsumsi sehingga memiliki nilai komoditas yang tinggi di pihak pembudidaya.
Namun dengan merebaknya bakteri Aeromonas hydrophila penyebab penyakit MAS, tingkat kematian ikan bernama ilmiah Oreochromis niloticus ini bisa berkisar antara 10 sampai 70 persen di kalangan pembudidaya. Sedangkan penyakit Streptococcosis yang disebabkan oleh infeksi bakteri Streptococcus bisa membuat kematian ikan nila berkisar 60 sampai 70 persen.
Dua penyakit bakterial ini juga dapat menyerang ikan nila secara bersamaan atau biasa disebut ko-infeksi. Kombinasi kedua penyakit ini menyebabkan kerusakan organ ginjal, otak, limfa, serta munculnya inflamasi atau luka-luka di bagian tubuh ikan nila. Gejala fisik ikan nila saat terjangkit ko-infeksi ini umumnya seperti mata menonjol, warna lebih kehitaman, dan perilaku pergerakannya yang berputar atau whriling.
Inilah yang menggerakkan para peneliti ikan air tawar di Balai Riset Perikanan Budidaya Air Tawar dan Penyuluhan Perikanan (BRPBATPP) Bogor milik Kementerian Perikanan dan Kelautan untuk mencari penangkal atas dua penyakit ikan nila yang mematikan ini.
Penelitian telah dimulai sejak 2012 silam. Kala itu, tim peneliti BRPBATPP melakukan screening terhadap master seed (isolate bakteri) unggulan dan menjalankan tahap demi tahap uji coba mulai dari uji efikasi, uji mutu dan produk di lapangan hingga diterbitkan ke jurnal ilmiah.

Penelitian panjang ini menghasilkan ramuan vaksin yang mampu menekan bakteri Aeromonas hydrophila dan Streptococcus hingga tak berkembang menjadi penyakit mematikan. Temuan tim riset BRPBATPP selama sadu dekade bekerja di Laboratorium Depok ini kemudian dipatenkan pada 2018. Namun permasalahannya, perlu ada hilirisasi produk atas temuan vaksin ikan nila agar dapat digunakan oleh masyarakat terutama para pembudidaya. Tanpa adanya proses produksi dan pengembangan, hasil penelitian ini hanya berhenti di laboratium dan jurnal ilmiah saja.
Mendapat Pendanaan Riset dari LPDP
Vaksinasi ikan memang terdengar belum cukup familiar di kalangan pembudidaya. Dibanding vaksin terhadap unggas atau hewan ternak lainnya, tindakan memvaksin ikan belum menjadi urgensi di kalangan pembudidaya ikan produksi. Kementerian Kelautan dan Perikanan kemudian meluncurkan Gerakan Vaksinasi Ikan atau Gervikan sejak tahun 2009. Tujuannya adalah untuk mendorong tindakan vaksinasi pada ikan guna mencapai tingkat kesehatan ikan yang optimal dan meningkatkan hasil panen.
Penelitian dan pengembangan vaksin ikan nila juga berkaitan dengan pemenuhan ragam vaksin ikan dalam program Gervikan. Sementara itu, mengembangkan penelitian vaksin agar bisa diproduksi dalam skala besar membutuhkan riset lanjutan yang membutuhkan dana besar.
Gayung bersambut, Lembaga Pengelola Dana Pendidikan (LPDP) memiliki program pendanaan riset bernama Riset Inovatif Produktif (RISPRO) yang bertujuan untuk membantu hilirisasi produk riset agar dapat digunakan di masyarakat. Tim peneliti vaksin ikan nila yang diketuai oleh Dr. Desy Sugiani, S.Pi, M.Si ini kemudian mengajukan proposal riset dan disetujui dengan durasi penelitian selama dua tahun dan telah dimulai pada 2019.
Total manfaat kelolaan #UangKita melalui Dana Abadi Penelitian yang mengalir untuk riset vaksin ikan nila ini sebesar Rp1.467.350.000. Pandemi Covid-19 yang sempat menghentikan perjumpaan fisik sempat memaksa durasi penelitian ditambah satu tahun.
“Riset Inovatif Produktif (RISPRO) berbasis komersial ini cocok sekali karena yang ditawarkan adalah memang untuk scale up produk yang sudah TKT-6 yang tingkat kesiapan teknologinya sudah level 6. Jadi sudah siap untuk diproduksi massal,” ujar Dr. Desy Sugiani saat ditemui di Laboratorium Biosafety Level 3 BRIN Cibinong pada Senin (11/12) pagi.

Komposisi peneliti vaksin ikan nila yang terdaftar dalam pendanaan program RISPRO Komersial datang dari berbagai disiplin ilmu biologi. Ada dari ahli mikrobiologi, ahli biologi molekuler, dan termasuk tim produksi. Sampai dengan durasi pendanaan selesai, Desy dan timnya berhasil merampungkan seluruh pekerjaan sesuai dengan indikator kinerja yang ditetapkan RISPRO LPDP.
Menggandeng Mitra Pembuat Vaksin Ikan
Syarat program pendaan RISPRO Komersial adalah menggandeng mitra fabrikasi untuk produksi hasil riset. PT Caprifarmindo Laboratories yang berada di Cimareme, Bandung Barat dipilih sebagai mitra yang memproduksi massal dan memasarkan vaksin ikan nila yang bernama Caprivac Hydrogalaksi. Anak perusahaan dari PT Sanbe Farma ini tertarik bermitra dengan BRPBATPP karena melihat volume produksi perikanan budidaya menunjukkan tren pertumbuhan yang signifikan.
“Kami memproduksi skala massal, di mana kapasitas kami ini adalah sebenarnya cukup besar, yaitu 1,2 juta dosis per bulan. Ikan nila ini adalah menjadi primadona untuk air tawar. Populasinya sangat besar.” ujar drh. Maryono selaku Plant Manager Veterinary Vaccine PT. Caprifarmindo Laboratories saat ditemui di kantornya.
Proses pembuatan vaksin di PT Caprifarmindo Laboratories diawali dengan derah terima Master Seed atau Working Seed bakteri A. hydrophila dan S. agalactiae pada 2020 di Bogor oleh BRPBATPP dan PT Caprifarmindo Laboratories. Kemudian dilakukan proses produksi bakteri atau perbanyakan skala industri meliputi inokulasi-harvest yang kemudian diinaktifasi dan diformulasi dalam bentuk larutan untuk memudahkan pengaplikasian baik secara injeksi (penyuntikan) maupun perendaman.
Berdasarkan hasil uji lapang, Vaksin Caprivac Hydrogalaksi menunjukan nilai relative percent survival (RPS) lebih dari 60 persen terhadap serangan bakteri A. hydrophila dan S. Agalctiae setelah dilakukan uji tantang. Vaksin Caprivac Hydrogalaksi juga dianggap aman karena tidak menyebabkan perubahan patologik dan tidak mengancam kelangsungan hidup ikan nila.
Ada dua cara pengaplikasian Caprivac Hydrogalaksi, yaitu melalui perendama dan injeksi. Teknik perendaman disarankan untuk ikan nila ukuran 30 gram ke bawah yang masih kategori benih. Sedangkan injeksi direkomendasikan untuk ikan nila calon induk atau yang sudah dewasa hingga ukuran siap panen.
Pemberian vaksin Caprivac Hydrogalaksijuga bisa dilakukan melalui media pakan ikan nila. Namun cara ini cenderung dipakai untuk kebutuhan vaksinasi ulang atau pemberian vaksin booster pada ikan nila.
Saat ini Caprivac Hydrogalaksi telah beredar di pasaran sejak pertama kali diluncurkan pada 2022. PT. Bina San Prima ditunjuk sebagai distributor Caprivac Hydrogalaksi yang tersebar di seluruh wilayah Indonesia.
Harga dari Caprivac Hydrogalaksi bervariasi antara antara 188 hingga 250 ribu rupiah tergantung lokasi pemasarannya. Desy menjelaskan bahwa harga Caprivac Hydrogalaksi masih terjangkau dan memberikan segudang manfaat bagi para pembudidaya ikan nila.
“Untuk per ekornya itu terkena mungkin sekitar 3 sampai 5 rupiah saja untuk metode perendaman. Jadi amat sangat ekonomis sekali kalau dibandingkan dengan harga benih. Dan manfaatnya nanti untuk melindungi ikan terhadap serangan ko-infeksi bakteri” ujar Desy.
Vaksin Bivalen Pertama di Indonesia pada Ikan Nila
Vaksin ikan nila buatan tim peneliti BRPBATPP yang kini melebur ke Pusat Riset Veteriner di Badan Riset dan Inovasi Nasional (BRIN) memanglah bukan yang pertama. Telah ada sebelumnya sejumlah vaksin untuk menangani penyakit yang menyerang ikan nila.
Namun, vaksin ikan di Indonesia yang mampu menangani dua penyakit bakteri sekaligus pada ikan nila barulah Caprivac Hydrogalaksi. Vaksin dengan kemampuan ganda ini disebut vaksin bivalent. drh. Arynta Widyaningrum selaku Bacterial Production Manager dari PT Caprifarma Laboratories menjelaskan, keuntungan vaksin bivalen dibanding monovalen antara lain adalah meminimalkan kemungkinan terjadinya stres saat vaksinasi karena tidak perlu melakukan dua kali tindakan.
“Vaksin bivalen Caprivac Hydrogalaksi cukup satu kali tindakan atau penyuntikan bisa mendapatkan protektivitas atau pertahanan tubuh yang maksimal terhadap dua penyakit sekaligus,” ujar Arynta.
Secara keseluruhan manfaat vaksin Caprivac Hydrogalaksi pada ikan nila adalah untuk meningkatkan daya tahan tubuh yang bisa berdampak pada peningkatan produksi, keamanan konsumsi atau pangan, dan keberlanjutan budidaya ikan nila itu sendiri.
Disinggung soal efek samping dari Caprivac Hydrogalaksi, Arynta bisa menyimpulkan bahwa tidak ada efek samping yang ditimbulkan pada ikan nila. Ia menjelaskan, efek samping bisa terjadi pada faktor penanganan saat tindakan vaksinasi. Apabila saat tindakan kurang memperhatikan langkah petunjuk penggunaan, maka memperbesar risiko stres dan menimbulkan efek samping pada ikan.

Saat ini vaksin Caprivac Hydrogalaksi telah menyebar di hampir seluruh wilayah Indonesia. Di Pulau Jawa, dari Banten sampai Jawa Timur telah ditemukan pembudidaya ikan nila yang menggunakan produk ini. Di luar Jawa seperti sebagian Sumatera, Sulawesi, Kalimantan, dan Nusa Tenggara Barat juga tercatat ada yang menggunakan vaksin Caprivac Hydrogalaksi.
Baik tim peneliti vaksin ikan nila maupun mitra riset PT Caprifarmindo Laboratories berharap adanya dukungan penyuluhan yang lebih masif kepada para pembudidaya ikan nila. Bahwa vaksinasi akan menghasilkan efek berlipat yang positif bagi sektor ekonomi, kesehatan, dan lingkungan.
Simak perbincangan lengkap dengan tim riset vaksin ikan nila di program LESSON yang tayang di YouTube LPDP RI berikut ini.



